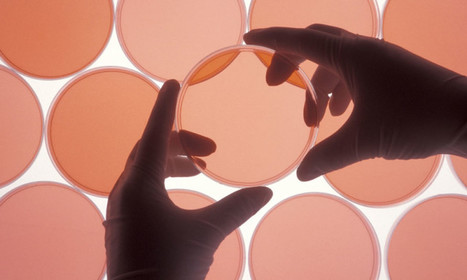
Center for Open Science Findings Raise Questions About Research Integrity - Associations Now | Peer2Politics | Scoop.it

Your new post is loading...

|
Scooped by
jean lievens
July 22, 2016 5:12 AM
|

|
Scooped by
jean lievens
April 16, 2016 6:45 AM
|
“Both brokering and boundary-spanning roles greatly increase the likelihood of leadership points to the importance of social positions that can unite open innovation communities. We argued that trust does not come easily to community members who fear cooptation by commercial interests or forking over technical disagreements. Because brokers by definition contrive less cohesive and less trusting contexts, the probability that they will assume leadership roles remains highly contingent on building trust with community members. We argue that aspiring leaders can build trust through physical attendance and, consistent with this argument, find a positive interaction with physical attendance. Also consistent with our emphasis on trust in open innovation communities, brokerage and boundary spanning demonstrated a negative interaction, indicating that brokers who span boundaries remain at a disadvantage. While brokerage alone demonstrates positive influence on becoming a leader, boundary spanning demonstrates a much stronger effect. Finally, we did not observe a contingent relationship between boundary spanning and attendance. Our results emphasize the importance of intermediary and integrating roles—for brokers within technological boundaries, and for boundary spanners across cohesive technological boundaries."

|
Scooped by
jean lievens
November 29, 2015 11:58 AM
|
Dr. Stephane Berghmans talks about open science and its requirements

|
Scooped by
jean lievens
October 29, 2015 1:55 AM
|

|
Scooped by
jean lievens
September 1, 2015 3:02 PM
|
A project carried out by the Center for Open Science found that more than half of the psychology studies it reviewed couldn't be successfully duplicated.

|
Scooped by
jean lievens
August 19, 2015 3:53 PM
|
Geography at Newcastle is a premier research area providing a major focus for social science and physical geography research and teaching within the School of Geography, Politics and Sociology.

|
Scooped by
jean lievens
August 15, 2015 3:16 PM
|
“Cultures of Anyone studies the emergence of collaborative and non-hierarchical cultures in the context of the Spanish economic crisis of 2008. It explains how peer-to-peer social networks that have arisen online and social movements such as the Indignadoshave challenged a longstanding cultural tradition of intellectual elitism and capitalist technocracy in Spain. From the establishment of a technocratic and consumerist culture during the second part of the Franco dictatorship to the transition to neoliberalism that accompanied the ‘transition to democracy,’ intellectuals and ‘experts’ have legitimized contemporary Spanish history as a series of unavoidable steps in a process of ‘modernization.’ But when unemployment skyrocketed and a growing number of people began to feel that the consequences of this Spanish ‘modernization’ had increasingly led to precariousness, this paradigm collapsed. In the wake of Spain’s financial meltdown of 2008, new ‘cultures of anyone’ have emerged around the idea that the people affected by or involved in a situation should be the ones to participate in changing it. Growing through grassroots social movements, digital networks, and spaces traditionally reserved for ‘high culture’ and institutional politics, these cultures promote processes of empowerment and collaborative learning that allow the development of the abilities and knowledge base of ‘anyone,’ regardless of their economic status or institutional affiliations.”

|
Scooped by
jean lievens
July 19, 2015 4:04 AM
|

|
Scooped by
jean lievens
July 7, 2015 1:31 PM
|

|
Scooped by
jean lievens
April 24, 2015 4:58 PM
|
"Despite of persistent efforts from the part of organizations aiming to solve or to alleviate the world’s most challenging issues, there are limitations of the current problem-solving system based on hierarchical bureaucratic models. These are mainly related to the powerlessness of the professional sector when, alone, facing global issues of ever increasing complexity and uncertainty. The current context often called “the network age” has in turn, supported and enhanced systems which serve as means for coping with these complex and uncertain scenarios, such as the concept of distributed cognition that leads (in its positive aspects) to collaborative, participatory and peer-to-peer common oriented processes, including the emergence of decentralized systems as well as the gradual empowerment of the civil society (overlapping with the latter); forming altogether, the background of latent paradigm shifts.

|
Scooped by
jean lievens
March 3, 2015 5:01 PM
|
"Turkers" are people who are essentially making their living by filling out questionnaires all day long, day after, month after month, year after year.

|
Scooped by
jean lievens
February 27, 2015 5:48 PM
|
"Open source and peer production have been praised as organisational models that could change the world for the better. It is commonly asserted that almost any societal activity could benefit from distributed, bottom-up collaboration — by making societal interaction more open, more social, and more democratic. However, we also need to be mindful of the limits of these models. How could they function in environments hostile to openness? Security is a societal domain more prone to secrecy than any other, except perhaps for romantic love. In light of the destructive capacity of contemporary cyber attacks, how has the Internet survived without a comprehensive security infrastructure? Secrecy vs. openness describes the realities of Internet security production through the lenses of open source and peer production theories. The study offers a glimpse into the fascinating communities of technical experts, who played a pivotal role when the chips were down for the Internet after large-scale attacks. After an initial flirtation with openness in the early years, operational Internet security communities have put in place institutional mechanisms that have resulted in less open forms of social production."

|
Scooped by
jean lievens
February 15, 2015 3:50 PM
|
* MA Thesis: 3D Printing, the Arts and Crafts Movement and the Democratization of Art. Lassi Patokorpi. University of Tampere, School of Language, Translation and Literary Studies, English Philology, April 2014
|

|
Scooped by
jean lievens
June 18, 2016 4:37 PM
|

|
Scooped by
jean lievens
April 11, 2016 1:21 PM
|
This short introduction tries to sketch out the scope and context of the Decentralized Society Research Project. http://dsrp.eu

|
Scooped by
jean lievens
November 22, 2015 10:36 AM
|
Seven Research-Based Principles for Making Organisations Work In The Seven Principles for Making Marriage Work, written with Nan Silver, renowned clinical psychologist and marriage researcher John ...

|
Scooped by
jean lievens
October 27, 2015 7:40 AM
|
"There are many threats as we move deeper into the anthropocene age. The dominance based hierarchies that have become an unquestioned part of 21st century life are a reflection of the linear profit driven paradigm that fails to see the interconnectedness between us, and between us and the world we inhabit. In order to find a pathway out of the looming dystopic futures that appear to be unfolding, a new paradigm that recognises the connectedness within nature and the social world is necessary to generate new social structures that can lead to more sustainable, thriving futures.

|
Scooped by
jean lievens
September 1, 2015 2:27 PM
|
"Despite of persistent efforts from the part of organizations aiming to solve or to alleviate the world’s most challenging issues, there are limitations of the current problem-solving system based on hierarchical bureaucratic models. These are mainly related to the powerlessness of the professional sector when, alone, facing global issues of ever increasing complexity and uncertainty. The current context often called “the network age” has in turn, supported and enhanced systems which serve as means for coping with these complex and uncertain scenarios, such as the concept of distributed cognition that leads (in its positive aspects) to collaborative, participatory and peer-to-peer common oriented processes, including the emergence of decentralized systems as well as the gradual empowerment of the civil society (overlapping with the latter); forming altogether, the background of latent paradigm shifts. Concurrently there is the political discourse (driven by the UN) on Sustainable Development Goals (SDGs) and of a Data Revolution, where the claim is that the latter is indispensable for achieving the former.

|
Scooped by
jean lievens
August 17, 2015 1:42 PM
|
Continual innovation in technologically mediated communications has excited social movement scholars, particularly over the past two decades. As a result there is now a great deal of empirical research detailing the uses of a variety of technologies by activists in a wide range of movements. However, the developing literature displays a number of conceptual problems and empirical gaps and we believe that addressing them could significantly advance our understanding of the interaction of movements with information and communication technologies (ICTs). We are calling for papers that address problems or gaps in the state of the art in scholarship on ICTs, digital media and social movements.

|
Scooped by
jean lievens
August 9, 2015 6:25 PM
|
"By adopting an action research methodology, I inquire into how far the responses of citizens to the global economic crisis of 2008 lead to the emergence of a new economic culture in Spain and Greece. Since Southern European states follow austerity directives and do not offer sufficient support for their population, communities organise to provide for each other through cooperation and solidarity. Decentralised political and economic movements are building structures to challenge and replace established centralised institutions. As people drop out of the formal economy, they find material relief, ideological support and a sense of belonging in networks of alternative economic practices."

|
Scooped by
jean lievens
July 14, 2015 4:11 PM
|
"Few issues in the rapidly expanding body of Degrowth research (e.g. D'Alisa et al., 2014, Sekulova et al., 2013 and Kallis et al., 2010) are as controversial and at the same time scientifically underexplored as the role of technology in the transition to a Degrowth society. The declaration of the Barcelona conference in 2010 called for selective moratoria on certain technologies (“Barcelona Declaration”, 2010), but discussions in Leipzig in 2014 were far from such a consensus. Two contrapositions were apparent: technology criticism following Illich, 1973, Elull, 1964 and Schumacher, 1973 and other critical authors versus technology enthusiasm that, for example, agrees with Gorz (1994) on the potential of digital fabricators. Ideas of simplification of life with less or low technology clash with visions of a true democratisation of society through the use of certain technologies (both high and low tech) such as open source programming, DIY tractors and photovoltaic panels. However, reality is not as “black and white” as it may seem. There is a wide range of potentially overlapping positions around scepticism and enthusiasm towards the role of technologies in Degrowth. This special volume aims to present and discuss these positions based on theoretical and empirical perspectives from authors with diverse backgrounds such as Science and Technology Studies, Philosophy of Technology, Ecological Economics, Industrial Ecology, Technology Assessment, Innovation Studies, Political Science and Anthropology. It focuses on how technology transforms ecology, society and the economy and emphasizes inter- and transdisciplinary approaches.

|
Scooped by
jean lievens
June 19, 2015 3:53 PM
|
"The rise in the usage and delivery capacity of the Internet in the 1990s has led to the development of massively distributed online projects where self-governing volunteers collaboratively produce public goods. Notable examples include Free and Open Source Software (FOSS) projects such as Debian and GNOME, as well as the Wikipedia encyclopedia. These distributed practices have been characterised as peer production, crowdsourcing, mass customization, social production, co-configurative work, playbour, user-generated content, wikinomics, open innovation, participatory culture, produsage, and the wisdom of the crowd, amongst other terms. In peer production, labour is communal and outputs are orientated towards the further expansion of the commons, an ecology of production that aims to defy and resist the hierarchies and rules of ownership that drive productive models within capitalism (Moore, 2011); while the commons, recursively, are the chief resource in this mode of production (Söderberg & O’Neil, 2014).

|
Scooped by
jean lievens
March 15, 2015 10:07 AM
|
As indicated before, the concept of integral is an umbrella term that can encompass different interpretations, though I believe that they share a commonality: that they are multi-perspectival, i.e. aim to combine not just one worldview, but several, or is meta-paradigmatical, incorporating more than one just one paradigm. The term transdisciplinarity is also closely related: it is not only the juxtaposing of different disciplines in one research project, but an attempt to transcend the partial approaches into a unity, an attempt to go “beyond” the different disciplines.

|
Scooped by
jean lievens
February 27, 2015 6:08 PM
|
"Open source and peer production have been praised as organisational models that could change the world for the better. It is commonly asserted that almost any societal activity could benefit from distributed, bottom-up collaboration — by making societal interaction more open, more social, and more democratic. However, we also need to be mindful of the limits of these models. How could they function in environments hostile to openness? Security is a societal domain more prone to secrecy than any other, except perhaps for romantic love. In light of the destructive capacity of contemporary cyber attacks, how has the Internet survived without a comprehensive security infrastructure? Secrecy vs. openness describes the realities of Internet security production through the lenses of open source and peer production theories. The study offers a glimpse into the fascinating communities of technical experts, who played a pivotal role when the chips were down for the Internet after large-scale attacks. After an initial flirtation with openness in the early years, operational Internet security communities have put in place institutional mechanisms that have resulted in less open forms of social production."

|
Scooped by
jean lievens
February 23, 2015 3:43 PM
|
Collective Awareness Platforms for Sustainability and Social Innovation (CAPS) - The EU Framework Programme for Research and Innovation
|
 Your new post is loading...
Your new post is loading...